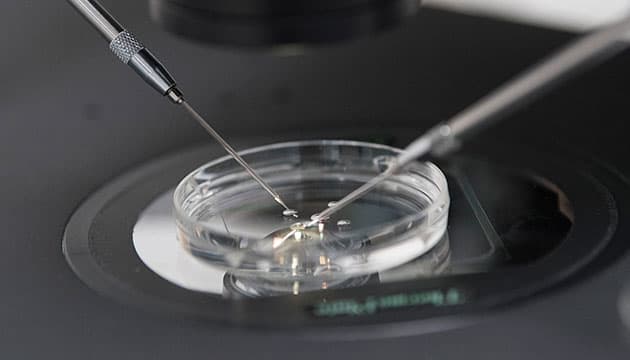
Foto: Lars Horn

Etiske guidelines til trods må man her på Aalborg Universitetshospital alligevel indimellem gå i den etiske tænkeboks og – om nødvendigt – sige nej til det mulige.
En særlig etisk problemstilling knytter sig til de par, der både er bærere af en arvelig alvorlig sygdom og har problemer med fertiliteten.
»Vi har oplevet at have par i behandling, hvor det ikke er lykkedes at blive gravide med raske embryoner. De har så efterfølgende ønsket, at vi implanterer et nedfrosset, sygt embryon. Det har vi afslået, selv om det ikke er svært at forstå deres motiv – de vil bare gerne være forældre. Og et sygt barn er i deres optik bedre end ingenting. Men vi skal ikke bidrage til skabelsen af et sygt barn«, siger Jakob Ingerslev og fortsætter:
»Det dilemma rejser naturligvis et væsentligt etisk spørgsmål: Hvem har retten til de befrugtede æg? Er det parret selv? Eller er det os? Vi har Styrelsen for Patientsikkerheds ord for, at vi traf den rigtige beslutning«.
Viden om, hvad der vælges fra
Tilbage til det unge par.
Det er ved den genetiske test af kvinden også blevet påvist, at hun har risiko for at være bærer af Wilsons sygdom, en sjælden, recessiv sygdom, hvor der sker en abnorm ophobning af kobber, særligt i lever og hjerne.
»Mange af sygdommene er så sjældne, at vi bliver nødt til at læse op på dem, når de bliver henvist. Der dukker masser af sygdomme op, som jeg i det mindste aldrig har hørt om«, siger Jakob Ingerslev.
Inden behandlingen kan sættes i værk, har parret været til samtale på en klinisk genetisk afdeling, hvor de er blevet informeret overordnet om, hvad PGT indebærer.
»Når de kommer her hos os, er det vores opgave at sikre, at de har en god forståelse af sygdommen. For flere af parrenes vedkommende er det lang tid siden, at de har været til klinisk genetisk rådgivning, og vi beder dem derfor om at fortælle det, de ved om sygdommen, så der er mulighed for at korrigere«, siger afdelingslæge, klinisk genetiker, Tue Diemer.
»Det er vigtigt, de forstår, at en sygdom kan præsentere sig forskelligt fra individ til individ. Og at den sygdom, de eventuelt har set hos et familiemedlem, måske ikke er den hyppigst forekommende måde, sygdommen manifesterer sig på.
Vores erfaring er, at det er meget forskelligt, hvordan vores patienter tolker alvoren af den samme sygdom. Det afhænger af, om de har set lette eller svære varianter af sygdommen«.
Gradualistisk etik
Da PGT blev et tilbud i sundhedsvæsenet, fik Center for Præimplantationsdiagnostik på Aarhus Universitetshospital udleveret en positivliste for sygdomme, som man måtte teste for.
På Rigshospitalet var det op til den lokale videnskabsetiske komité at afgøre, hvad der måtte undersøges for, og her fik man i første omgang ubegrænset tilladelse til at anvende PGT.
I en redegørelse fra 1999 blev antallet af sygdomme, der kunne diagnosticeres for, opgjort til 51.
»Myndighederne måtte erkende, at det ikke giver mening at operere med en positivliste, som jo heller ikke findes for prænatal diagnostik. De arvelige sygdomme manifesterer sig forskelligt fra familie til familie og fra individ til individ. Desuden er det umuligt at definere alvorlighed som et entydigt kriterium.
I dag læner vi os op ad de kriterier, der anvendes i forbindelse med prænatal diagnostik. Men det giver sig selv, at ingen vil gå igennem et behandlingsforløb, hvis der er tale om en sygdom, der ikke har væsentlig betydning for livskvaliteten«, siger Jakob Ingerslev.
Da det første par på centeret i Aalborg fik gentestet deres embryoner, var indikationen medfødt grå stær. En lidelse, som nogle måske ikke vil henregne under kategorien »alvorlige sygdomme«, men tilstanden kan medføre nedsat syn og ultimativt blindhed.
»Parret havde i forvejen to børn, der var blevet opereret for sygdommen. Imidlertid døde det ene barn under narkosen, men blev heldigvis genoplivet. En oplevelse, der satte sig spor i denne familie, der havde fået et andet syn på en relativ harmløs sygdom«, siger Tue Diemer.
Men der er ifølge Jakob Ingerslev også andre grænsetilfælde.
»Familiær polypose, der indebærer risiko for at udvikle tarmkræft eller BRCA-mutationer, der øger risikoen for bl.a. brystkræft, er jo ikke i sig selv invaliderende lidelser, men sygdomme man i vidt omfang kan kontrollere sig ud af. I hvert fald set udefra. For dem, der er i det, kan det være særdeles belastende«, siger Jakob Ingerslev.
Ud over onkogener er der andre tilstande, hvor præimplantationsdiagnostik måske kan være etisk lettere at vælge end prænatal diagnostik. Det gælder f.eks. familier med risiko for Huntingtons chorea.
Mange vordende forældre, der har en nær slægtning med sygdommen, vil ikke vide, om de er bærere af den sygdomsfremkaldende Huntingtons chorea-variant. I de tilfælde er det ved en indirekte test muligt at se, om det spæde foster er i risiko for at arve varianten, samtidig med at forældrenes ønske om at forblive uvidende om deres egen risiko respekteres.
»Den indirekte teknik indebærer imidlertid, at halvdelen af de fravalgte fostre er raske. Her spiller det nok en betydelig rolle for parrene, om det er fostre i uge 11, der aborteres, eller embryoner på blastocyststadiet fem døgn efter befrugtningen.
Dette er helt i overensstemmelse med den såkaldt gradualistiske etik, vi praktiserer her i landet, og som betyder, at jo længere i udviklingen fosteret er, jo mere respekt skal man vise det«, siger Jakob Ingerslev.
Fra Aarhus til Aalborg
Jakob Ingerslev var i en længere årrække leder af Center for Præimplantationsdiagnostik på Aarhus Universitetshospital. Men i en sparerunde i 2015 besluttede de midtjyske regionspolitikere at lukke fertilitetsklinikken, og ved den lejlighed mistede regionen også PGT-funktionen. En beslutning, som Jakob Ingerslev den dag i dag ikke forstår.
»Erhvervsaktive mennesker skulle nu køre til Skive og Horsens for at komme i fertilitetsbehandling. Jeg begreb aldrig helt, hvad den dagsorden handlede om.
Da PGT-funktionen naturligvis skal ligge på et universitetshospital, kontaktede jeg den daværende ledende overlæge på Aalborg Universitetshospital, og han tøvede ikke et øjeblik, da jeg luftede idéen om, at man i Aalborg skulle etablere et center for præimplantationsdiagnostik.
Jeg mødte heroppe et ungt universitetshospital, hvor folk på alle niveauer udstrålede et engagement, som jeg ikke havde mødt i årevis«, siger Jakob Ingerslev om etableringen af det murstensløse center, som altså blev en realitet i 2016.
Og selv om tanken var, at han blot skulle være fødselshjælper for centret, endte han med at blive hængende.
»Nu er der så to centre her i landet: et på henholdsvis Rigshospitalet og Aalborg Universitetshospital, som hver har en kapacitet, som er stor, robust og tilstrækkelig til at dække behovet i Danmark. Det blev en dyr ,besparelse’ for Region Midtjylland«, siger Jakob Ingerslev.
Etableringen af det nye center på Aalborg Universitetshospital gav lejlighed til en gennemgribende opdatering af teknikken, og centeret arbejder løbende på at forfine metoderne.
I dag tages der en celleprøve på 5-10 celler på blastocyststadiet, hvor det befrugtede æg er cirka fem dage gammelt og indeholder cirka 100 celler. Tidligere blev undersøgelsen udført på én celle udtaget på tredjedagen, hvor der kun er omkring otte celler.
Under mikroskop laves et hul i »skallen« omkring embryonet, og der trækkes derpå en snip af den tidlige moderkage ud og afklippes med laseren. Embryonet nedfryses, og derefter undersøges cellerne for familiens arvelige sygdom.
I langt de fleste tilfælde kan ægget holde til biopsien. Men det hænder en sjælden gang, at ægget går itu.